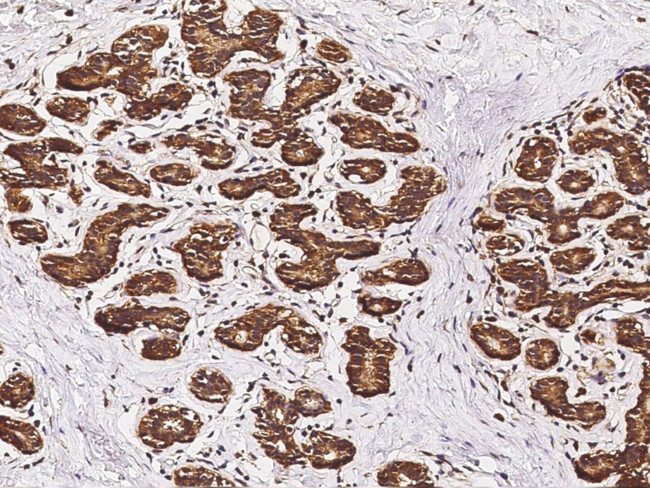
B7-H4 Antibody in Immunohistochemistry (Paraffin) (IHC (P))

Search
Invitrogen
B7-H4 Polyclonal Antibody
{{$productOrderCtrl.translations['antibody.pdp.commerceCard.promotion.promotions']}}
{{$productOrderCtrl.translations['antibody.pdp.commerceCard.promotion.viewpromo']}}
{{$productOrderCtrl.translations['antibody.pdp.commerceCard.promotion.promocode']}}: {{promo.promoCode}} {{promo.promoTitle}} {{promo.promoDescription}}. {{$productOrderCtrl.translations['antibody.pdp.commerceCard.promotion.learnmore']}}
产品信息
PA5-81119
宿主/亚型
分类
类型
抗原
偶联物
形式
浓度
规格
保存条件
运输条件
RRID
产品详细信息
This product is preservative free. It is recommended to add sodium azide to avoid contamination (final concentration 0.05%-0.1%).
This antibody has specificity for Human B7-H4/B7S1/B7x.
靶标信息
B7-H4 (B7x, VTCN1) a costimulatory protein which is reported to function as a negative regulator of T-cell mediated immunity. Although B7-H4 binds an unknown receptor, it is thought to deliver an inhibitory signal to T-cells preventing their proliferation, cell cycle progression and interleukin-2 production. B7-H4 deficient mice are only minimally affected; suggesting B7-H4 is important in the fine tuning of the T-cell mediated immune response. B7-H4 is expressed on activated T-cells, B-cells, monocytes and dendritic cells. Aberrant expression has been associated with cancers of the lung, breast and ovary in humans. B7-H4 is expressed primarily on the membrane of lymphoid cells, and as an immunoinhibitory protein that interacts with receptors on the surface of T lymphocytes, it is involved in mediating cellular and humoral immune responses. Overexpression of B7-H4 is associated with certain malignancies, including ovarian and breast cancer, which may be a mechanism by which tumor cells suppress T cell immunity and facilitate tumor progression. Further, VTCN1 may be a useful biomarker for the early detection of ovarian cancer and Renal Cell Carcinoma (RCC).
仅用于科研。不用于诊断过程。未经明确授权不得转售。